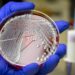

A 2ª Vara de Falências e Recuperações Judiciais do Tribunal de Justiça de São Paulo aprovou nesta segunda-feira (20) o pedido de recuperação judicial da varejista de eletrodomésticos Polishop, cujo valor da ação soma quase R$ 400 milhões.
Na decisão, o juiz Paulo Furtado de Oliveira Filho diz que a Polishop preenche os requisitos legais para o requerimento. Com isso, ficam suspensas execuções, arrestos e penhoras contra a empresa por um período de 180 dias.
A administradora judicial, Cabezón Administração Judicial, deverá apresentar, em 48 horas, um termo de compromisso e, em 15 dias, uma proposta de trabalho e remuneração, além do primeiro relatório sobre o andamento do processo.
A varejista também foi instruída a apresentar contas mensais e documentos relevantes, como extratos bancários e comprovantes de recolhimento de impostos e encargos sociais.
Um edital será publicado para que os credores apresentem habilitações ou divergências no prazo de 15 dias, diretamente à administradora judicial, de acordo com o processo.
A Polishop, que de acordo com seu site possui 54 pontos de venda no Brasil, não respondeu de imediato a pedido de comentário da Reuters.

Comentários sobre este post